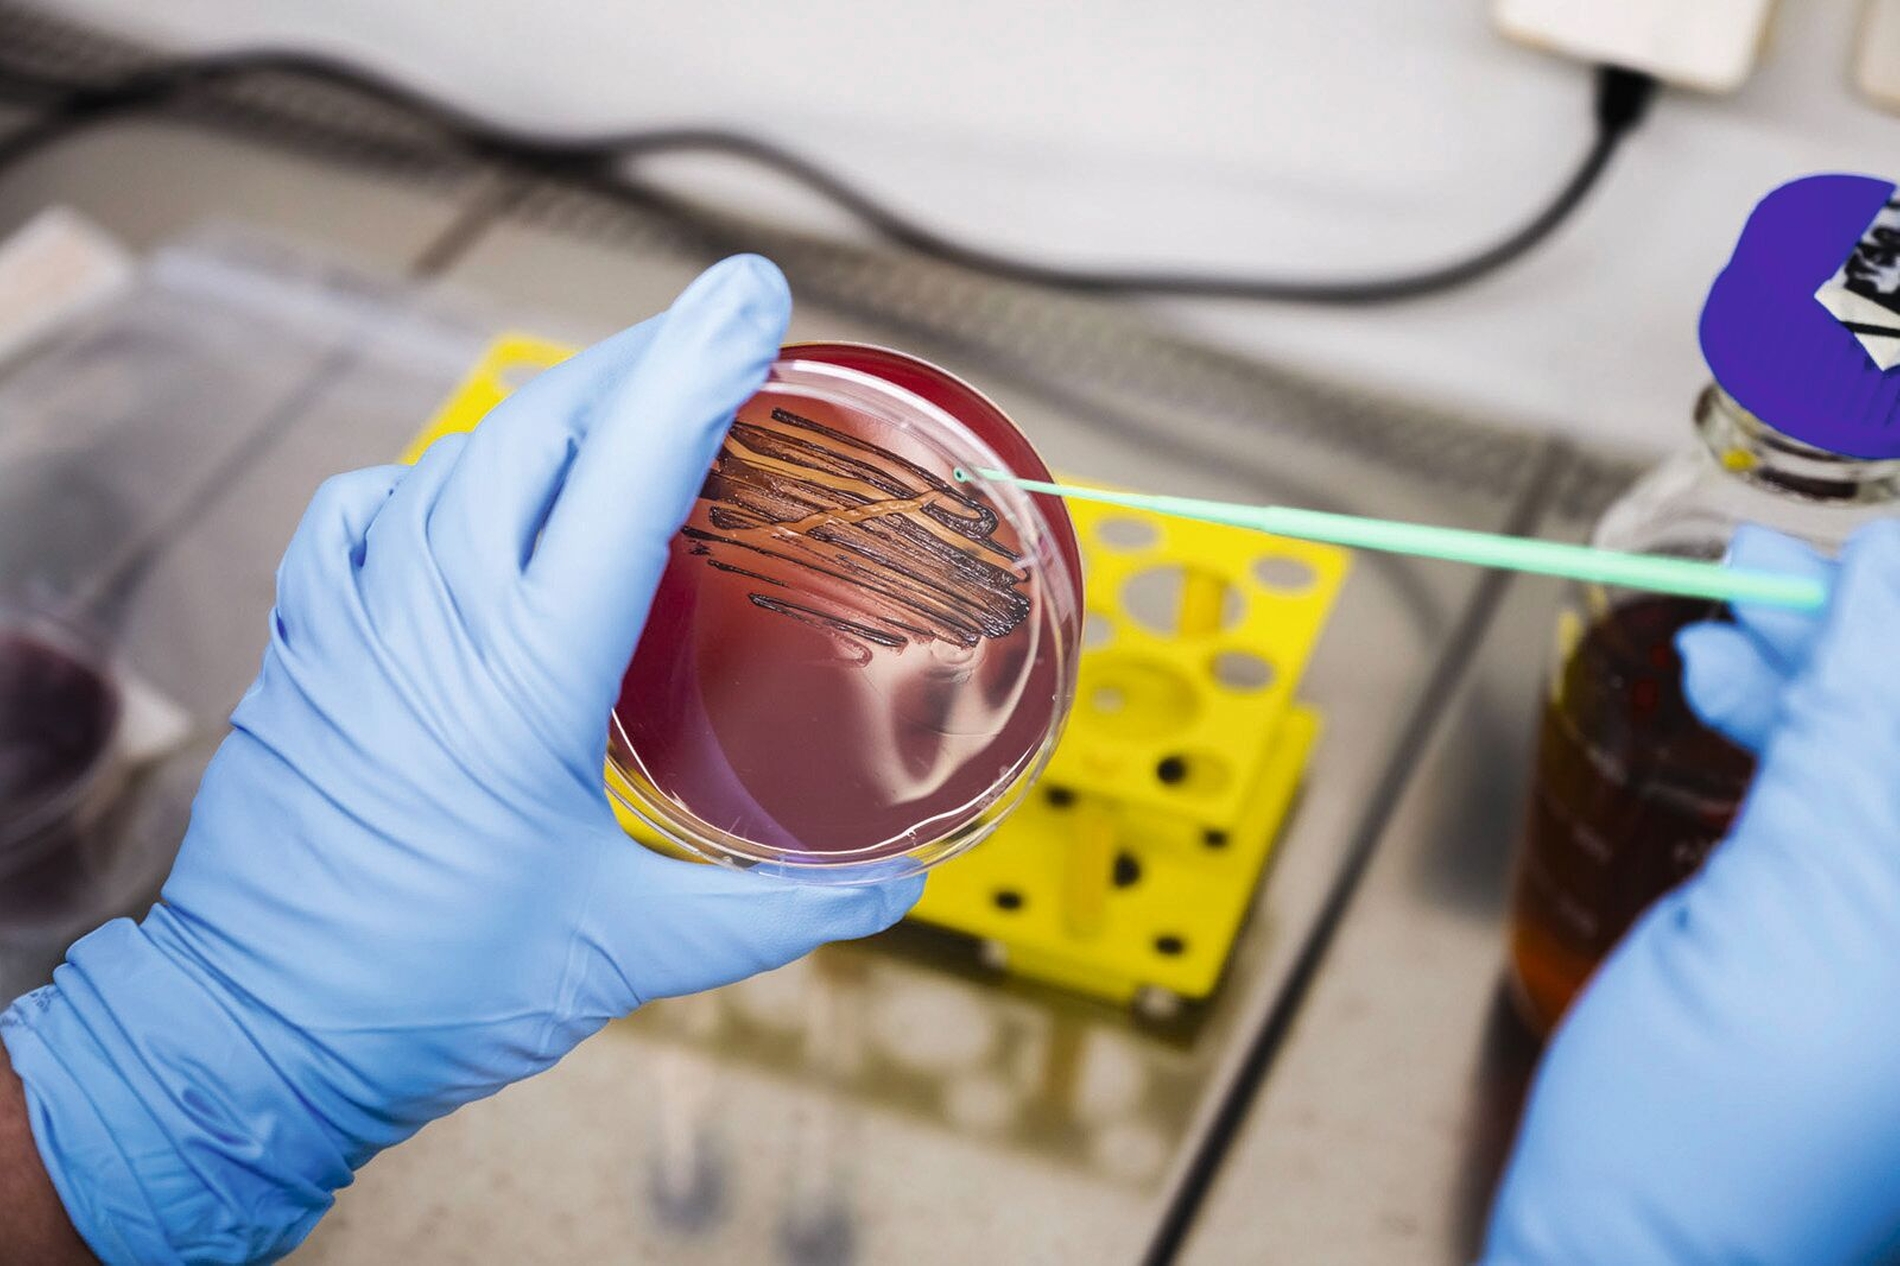
Überimpfen einer P. gingivalis-Probe nach Kultivierung zur weiteren Testung des Wirkstoffes. Die Bakterien werden im Labor auf Petrischalen auf einem Nährmedium (Agar) gezüchtet.

Stoppt diese Zahnpasta Parodontitis?
Das orale Mikrobiom beherbergt mehr als 700 verschiedene Bakterienarten. Einige wenige können Parodontitis verursachen, die neben oralen Effekten auch die Entstehung von Diabetes, Rheuma, Arthritis, Herz-Kreislauf-Erkrankungen, chronisch entzündlichen Darmerkrankungen und sogar Alzheimer begünstigen können, erinnern die Wissenschaftler in einer Mitteilung.
Herkömmliche Mundpflegeprodukte, etwa als Mundspülungen mit Alkohol oder mit dem Antiseptikum Chlorhexidin, vernichteten zwar die Pathogene, aber eben auch alle anderen Keime. „Wenn sich die Mundflora nach der Behandlung wieder aufbaut, haben pathogene Keime wie Porphyromonas gingivalis einen Startvorteil, weil sie sich auf entzündetem Zahnfleisch besonders gut vermehren können“, berichten die Forschenden. „Die gesunden Keime hingegen wachsen langsamer, und die Mundflora kippt schnell wieder aus dem natürlichen Gleichgewicht in eine Dysbiose – die Krankheit kehrt immer wieder zurück.“
Mehr als zehn Jahre Entwicklung stecken im Mikrobiom-modulierenden Ansatz
Die Idee entstand im Austausch zweier Experten ihrer jeweiligen Disziplinen: Prof. Jan Potempa erforscht seit Jahren parodontale Pathogene, insbesondere Porphyromonas gingivalis, während Prof. Hans-Ulrich Demuth mit seinem Team an einem neuartigen Ansatz in der Alzheimer-Forschung arbeitete. Sie stellten fest, dass beide mit ähnlichen Eiweißstoffen befasst waren, die jedoch unterschiedliche Auswirkungen haben.
2013 griff ein EU-gefördertes größeres Konsortium diesen Ansatz auf und unter Leitung des Fraunhofer-Instituts für Zelltherapie und Immunologie – Molekulare Wirkstoffbiochemie und Therapieentwicklung (IZI-MWT) wurde der bakterielle Typ II Glutaminyl-Cyclasen (PgQC) als zentraler Virulenzfaktor von P. gingivalis identifiziert [Bochtler et al., 2018; Taudte et al., 2021; Szceśniak et al., 2023]. Erste Inhibitoren zeigten, dass eine gezielte Hemmung möglich ist und die erhaltenen Verbindungen nicht cytotoxisch waren [Ramsbeck et al., 2021].
Mit der Gründung der PerioTrap Pharmaceuticals GmbH im Jahr 2019 begann die Überführung der Forschungsergebnisse in praxisgerechte Produkte. In-vitro- und Biofilm-Studien bestätigten die Wirksamkeit der Technologie. Zentrale Arbeiten untersuchten den Inhibitor S-0636 in planktonischen P.-gingivalis-Kulturen, wo er gezielt Virulenzfaktoren hemmte, ohne bakterizid zu wirken [Taudte et al., 2025]. Kommensale Bakterien reagierten fast gar nicht auf die Substanz. Parallel dazu konnte die Effektivität in komplexen 12-Spezies-Biofilmen nachgewiesen werden: Die Aktivität der Virulenzfaktoren, die Biofilmmasse und die proinflammatorischen Reaktionen nahmen deutlich ab, während die kommensalen Bakterien geschont wurden [Eick et al., 2025].
Diese Befunde bilden die wissenschaftliche Basis der PerioTrap-Technologie und belegen, dass krankmachende Eigenschaften von P. gingivalis gezielt moduliert werden können, ohne das orale Mikrobiom zu beeinträchtigen. Die Substanz wurde gemäß den europäischen Vorgaben auf Sicherheit und Verträglichkeit geprüft. Die entwickelten Produkte wurden in Zusammenarbeit mit dem Fraunhofer-Institut für Mikrostruktur von Werkstoffen und Systemen (IMWS) Materialuntersuchungen unterzogen. Aktuell werden klinische Studien durchgeführt, während neue Formulierungen – etwa eine Mundspüllösung – für den professionellen und den häuslichen Einsatz entwickelt werden.
Dr. Mirko Buchholz, Apotheker und Chief Scientific Officer bei der PerioTrap Pharmaceuticals GmbH
Die Zahnpasta blockiert das Wachstum des Erregers
Prof. Stephan Schilling, Leiter der Fraunhofer-IZI-Außenstelle Molekulare Wirkstoffbiochemie und Therapieentwicklung, erklärt die besondere Wirkweise der Substanz mit dem Namen Guanidinoethylbenzylamino Imidazopyridine Acetat so: „Sie tötet die Gingivitis-Erreger nicht einfach ab, sondern blockiert nur deren Wachstum." Schilling weiter: „Sie können ihre giftige Wirkung nicht entfalten, und die gesunden Keime können ihnen sonst verwehrte Nischen besetzen. So hilft der Stoff im Einklang mit den gesunden Bakterien, das mikrobielle Gleichgewicht im Mund sanft aufzubauen und stabil zu halten.“
Die Basis der Technologie geht auf ein EU-Projekt zurück, an dem viele internationale Partner beteiligt waren. Für die Entwicklung neuartiger Zahnpflegeprodukte wurde 2018 das Spin-off PerioTrap Pharmaceuticals GmbH gegründet, ebenfalls mit Sitz in Halle. In enger Zusammenarbeit mit dem Fraunhofer IZI und dem Fraunhofer-Institut für Mikrostruktur von Werkstoffen und Systemen IMWS entstand die Mikrobiom-Zahnpasta von PerioTrap.
„Das Produkt dient der Vorbeugung von Parodontitis. Wie eine normale Zahnpasta enthält es aber auch Putzstoffe und Fluorid zur Vorbeugung von Karies“, erklärt Dr. Mirko Buchholz, einer der Gründer des Fraunhofer-Spin-offs.
„Eine Zahnpasta mit einem solchen Wirkstoff kann keine Parodontitistherapie ersetzen!“
„Die Deutsche Gesellschaft für Parodontologie (DG PARO) begrüßt innovative Forschungsansätze, die darauf abzielen, parodontopathogene Keime gezielt anzugehen und dabei das ökologische Gleichgewicht des oralen Mikrobioms zu berücksichtigen. Der Wirkstoff Guanidinoethylbenzylamino-Imidazopyridin-Acetat stellt einen solchen neuartigen Ansatz dar, da er nicht breit antimikrobiell wirkt, sondern selektiv auf zentrale Virulenzmechanismen von Porphyromonas gingivalis abzielt.“
Und weiter: „Für diesen Wirkmechanismus liegen mittlerweile belastbare präklinische Daten aus unabhängigen, sehr erfahrenen Forschungslaboren vor, die zeigen, dass durch die Hemmung der bakteriellen Glutaminylcyclase pathogene Eigenschaften von P. gingivalis abgeschwächt werden können, ohne die gesamte orale Mikroflora zu beeinträchtigen. Diese Laborstudien bilden eine wissenschaftlich nachvollziehbare Grundlage für das Konzept einer mikrobiomschonenden Prävention.“
Gleichzeitig betont die DG PARO ausdrücklich, dass eine Zahnpasta mit einem solchen Wirkstoff keine Parodontitistherapie ersetzen kann. „Die Behandlung der Parodontitis erfordert weiterhin eine strukturierte, systematische Therapie, die auf professioneller Diagnostik, mechanischer Biofilmentfernung und unterstützender Nachsorge basiert.“
„Der Einsatz innovativer Zahnpflegeprodukte mit selektiver antibakterieller Wirkung sollte daher immer im Kontext einer zahnärztlich oder dentalhygienisch begleiteten Parodontitistherapie erfolgen und individuell mit der behandelnden Zahnärztin, dem behandelnden Zahnarzt oder der Dentalhygienikerin beziehungsweise dem Dentalhygieniker besprochen werden.“
Darüber hinaus weist die DG PARO darauf hin, dass die klinische Wirksamkeit und der Zusatznutzen solcher Wirkstoffe bislang nicht durch randomisierte kontrollierte klinische Studien belegt sind. „Entsprechende klinische Daten sind erforderlich, um den Stellenwert dieser Substanzen in der Prävention und der unterstützenden Therapie evidenzbasiert bewerten zu können.“
Die DG PARO sieht im vorgestellten Wirkprinzip „ein interessantes und potenziell zukunftsweisendes Konzept, dessen weitere wissenschaftliche und klinische Evaluation ausdrücklich zu begrüßen ist“.
„Durch rasterelektronenmikroskopische Aufnahmen, chemische Charakterisierung und quantitative Messungen können wir detaillierte Aussagen über die Verträglichkeit und Funktion einer Substanz machen", erläutert Dr. Andreas Kiesow, Gruppenleiter Charakterisierung medizinischer und kosmetischer Pflegeprodukte.
Es gibt auch schon ein Gel, ein Mundwasser ist in der Mache
Für den Einsatz in der Zahnarztpraxis haben die Expertinnen und Experten des Spin-offs PerioTrap gemeinsam mit den Fraunhofer-Instituten ein Pflege-Gel entwickelt, das nach der Professionellen Zahnreinigung appliziert werden kann. Es soll pathogene Bakterien blockieren, die Mundflora stabilisieren und das Zahnfleisch gesund halten. Derzeit arbeiten die Forschenden an einem Mundwasser.